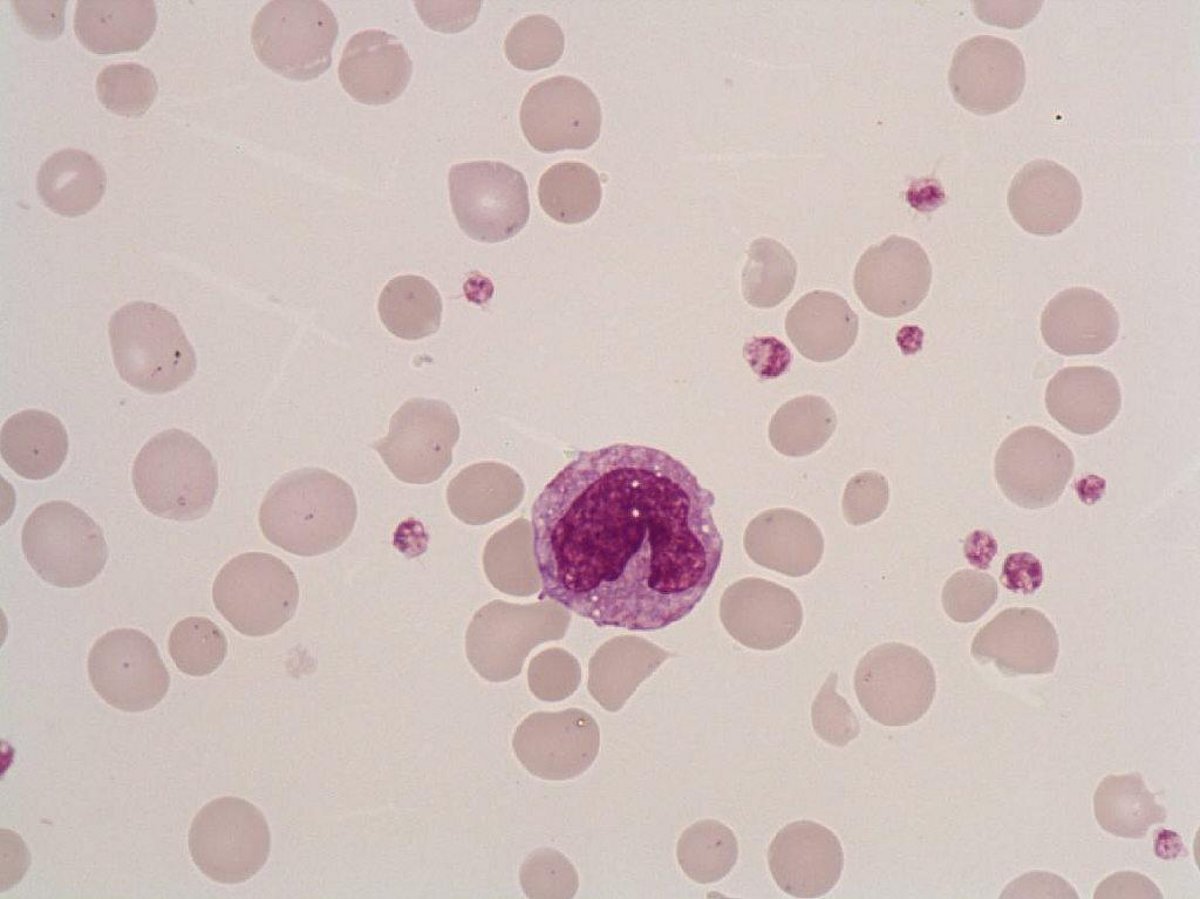
Monocyte

Large size cell, very irregular horseshoe- shaped nucleus, hammered-metal appearance or combed chromatin, no nucleolus, gray stormy sky cytoplasm, sometimes lipidic vacuoles and fine azurophilic granules.
Reactive Monocytosis (most common cause).
Acute monoblastic leukemia: AML5b> AML5a, Acute myelomonocytic leukemia AML4 (monocytes >5G/L or > 20% in the bone marrow).
Chronic myelomonocytic leukemia CMML,Monocytosis associated with CML or other MPS.